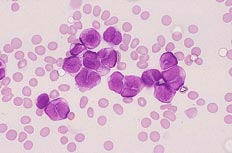

症例14
| 年齢 | 10歳代 | |||
|---|---|---|---|---|
| 現病歴 | 発熱、倦怠感にて来院、末梢血にて異常細胞?がみられ、精査のため入院となる. | |||
| 血液学所見 | WBC(/μL) | 5,670 | RBC(万/μL) | 384 |
| Hb(g/dL) | 11.7 | Ht(%) | 38.3 | |
| PLT(万/μL) | 18.7 | MCV(fL) | 99.7 | |
| MCH(pg) | 30.4 | MCHC(%) | 30.5 | |
| 血液像(%) | Promy 2 ,St-Seg 71, Ly 25, Eo 2 | |||
| 骨髄所見 | NCC(万/μL) | 13.5 | MgK(/μL) | 0 |
| Blast様(%) | 99.0 | |||
| 生化学所見 | LDH 189 U/L, CRP 0.12 mg/dL | |||
| 表面形質 | CD13,CD33(+) HLA-DR(−) | |||
![]() |
![]() |
|
|---|---|---|
| [骨髄×400.MG染色] 芽球様細胞は核形不整がみられる. |
[骨髄×1000.MG染色] 芽球様細胞は、核形不整が顕著であり、大きな切れ込みがみられる. |
|
![]() |
![]() |
|
| [骨髄×1000.MG染色] 芽球様細胞には顆粒のないものから微細な顆粒を有するものがみられる. |
[骨髄×1000.PO染色] 芽球様細胞はPO染色に陽性(一部強陽性)より、病的前骨髄球と思われる. |
|
![]() |
||
| [骨髄×400.EST染色] EST二重染色ではN-ASD-CLA染色に陽性である. |
||
正解 : 4 急性前骨髄球性白血病(15;17転座)
拡大した形態画像には、解説が含まれています。
| 年齢 | 10歳代 |
|---|---|
| 〜前発信〜 | |
| 末梢血所見から | 軽度の貧血の精査で幼若顆粒球との鑑別が困難な異常細胞がみられる. |
| 骨髄所見から | 骨髄は正形成で芽球様細胞は核形不整が顕著で、顆粒は全般に少なく、一部には少数認めるものもある. |
| 細胞化学所見から | 芽球様細胞はPO染色に強陽性で、EST染色ではN-ASD・CLA染色に陽性で、α-NB染色に陰性である. |
| 【形態診断】 | 芽球様細胞は一見単球を思わせるものであったが、PO染色が強陽性やEST染色(α-NB染色)が陰性より異常(病的)の前骨髄球を疑った. 核形不整は強く、顆粒が少ないことでAML-M3 variant formを考えた. |
| 〜後発信〜 | |
| 分子生物学的から | 46,XX,t(15;17)(q22;q11) PML::RARA gene(+) |
| 【臨床診断】 | 光顕的所見よりAML-M3を考え、顆粒の出現が少ないことより M3variantとして診断された. 後報告の染色体検査でそれを支持する核型異常が認められた. |
| WHO分類(2022) | 遺伝子異常で定義されるAML ☆PML::RARA融合遺伝子を有するAML |